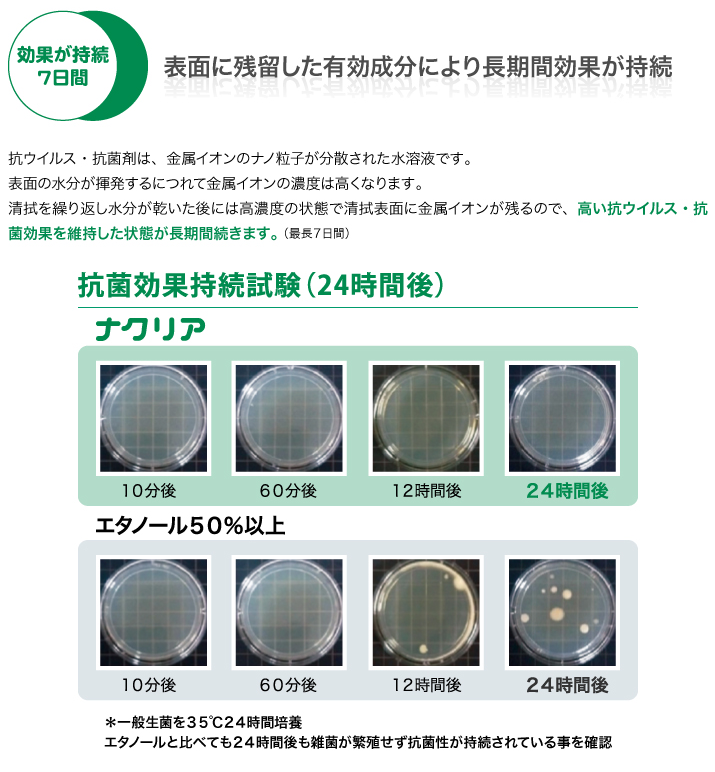
ナクリア&reg;特徴

製品情報
製品や施工に関するご不明点や
お悩みに関して
お問い合わせください

ナクリア®とは

ナクリア®特徴
必須ミネラルである金属イオンの効果とは
金属イオンには、細胞内の酸素を活性酸素化させる事で細胞膜を破壊し、ウイルスや細菌を不活化させる効果があります。ナクリアは、その帰属イオンを有機酸水溶液へ効果的に分散、酸化させる事で安定化させ、より安全に使えるようにしました。さらに、この酸化させた金属イオンをナノ粒子化させる事で、ウイルスおよび細菌表面の接触面積を増やして抗ウイルス・抗菌効果を高めています。
動植物の必須ミネラルが主成分なので毒性や殺菌性による不活化ではなく、人体や環境に対して安全です。
除菌剤に第4級アンモニウム塩やアルコールを一切使用していないため環境表面にダメージを与えません。ユニット周りやレントゲン機器類などの高価な器材の清拭にも安心してお使いいただけます。

ナクリア®商品仕様

ナクリア®使用上の注意と用途

ナクリア®販売
下記のインターネットショップからご購入が可能です。



